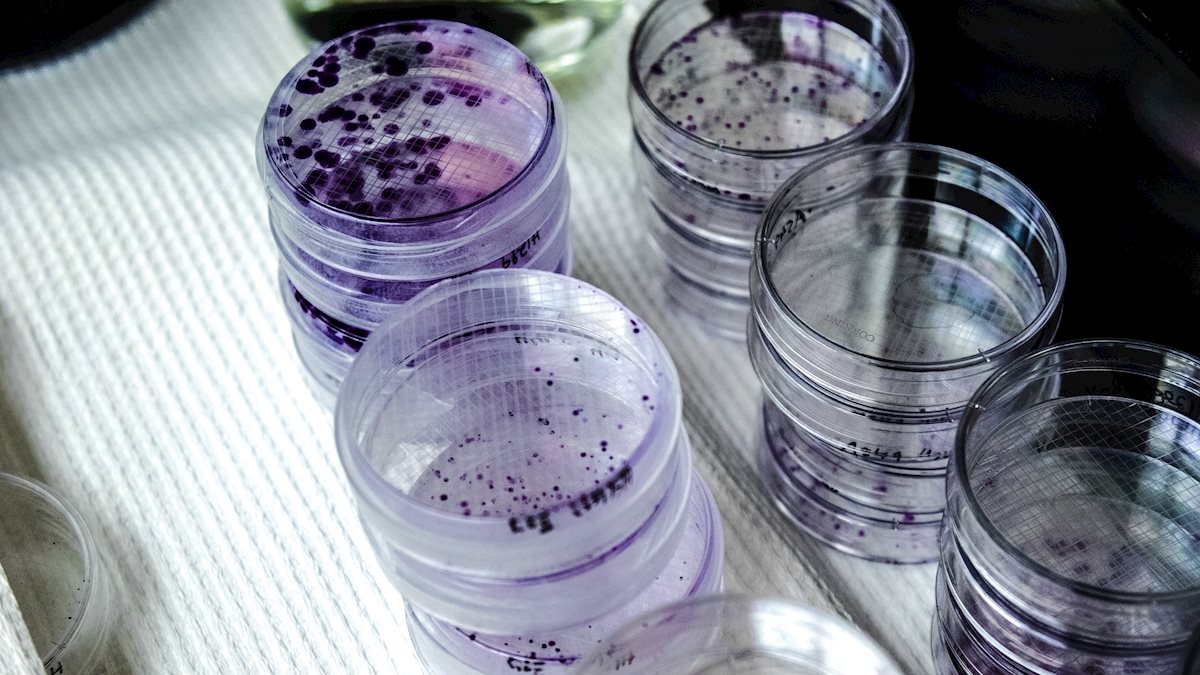

Could Coronavirus Turn Into Zombies


Experiencing The Coronavirus Pandemic As A Kind Of Zombie Apocalypse By Lorrie Moore The New Yorker
www.newyorker.com

Exclusive The Pentagon Has A Plan To Stop The Zombie Apocalypse Seriously Foreign Policy
foreignpolicy.com

Review Sony S New Days Gone Ps4 Game Brings A Zombie Apocalypse To The Pacific Northwest Geekwire
www.geekwire.com

Opinion Acting In The Walking Dead Didn T Prepare Me For Coronavirus The New York Times
www.nytimes.com

Corona Zombies The Terrible Movie We Might Just Need Right Now Film The Guardian
www.theguardian.com










/cdn.vox-cdn.com/uploads/chorus_image/image/66505513/GettyImages_1212627694.0.jpg)















:no_upscale()/cdn.vox-cdn.com/uploads/chorus_image/image/66509502/wwz.0.jpg)

/cdn.vox-cdn.com/uploads/chorus_asset/file/14127204/GettyImages_911536146.jpg)













